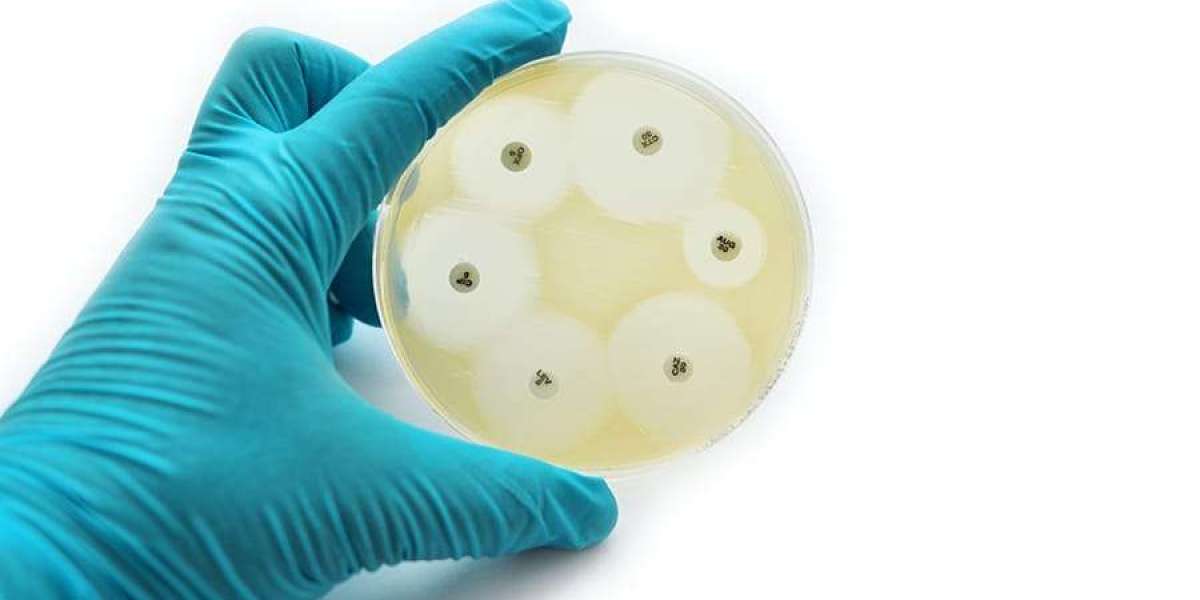

For a UK business aiming to compete on the global stage, the ability to hire the best international talent is not just an advantage; it is a necessity. Securing a Home Office sponsor licence is the critical first step that unlocks this global talent pool. However, it is a common and dangerous misconception to view the licence as a one-time administrative hurdle. In reality, being granted a sponsor licence is the beginning of a long-term and demanding partnership with the Home Office.
The Home Office grants you this licence based on a position of immense trust. They are, in effect, delegating a portion of the UK's immigration control directly to you, the employer. This trust comes with a heavy burden of responsibility and a set of strict, ongoing duties. A failure to meet these duties can have catastrophic consequences for your business. At Immigration Solicitors4me, our dedicated team of Business immigration solicitors acts as an expert compliance partner for UK companies, helping them to manage this burden with confidence and security.
Why Are Your Sponsor Duties Taken So Seriously?
The Home Office's entire sponsorship system is designed to ensure that the immigration rules are not being abused. They need to be certain that the jobs you are offering are genuine, that the migrant workers you sponsor are complying with their visa conditions, and that your business is a responsible and trustworthy partner. Any breach of your duties is seen not just as an administrative error, but as a failure of this delegated trust, which is why the penalties for non-compliance are so severe.
The Duty of Meticulous Record-Keeping: Your Evidentiary Shield
Your first and most fundamental duty is to maintain a detailed and up-to-date HR file for every single sponsored worker you employ. This is not just good HR practice; it is a specific legal requirement. In the event of a Home Office compliance audit, this file will be your primary evidentiary shield. The file must contain, among other things:
- A full copy of the sponsored worker's passport and visa.
- Their up-to-date contact details.
- A record of their absences and attendance.
- Copies of their payslips to prove they are being paid the correct salary.
Reporting Responsibilities: When Must You Inform the Home Office?
You have a proactive duty to report a range of specific events and changes relating to your sponsored workers. These reports must be made via the online Sponsor Management System (SMS), usually within 10 working days of the event. Key reportable events include:
- If a sponsored worker does not show up for their first day of work.
- If a worker is absent from work for more than 10 consecutive days without permission.
- If there are any significant changes to the worker's job, such as their title, core duties, or salary.
- If the worker's employment is terminated, or if they resign.
Keeping on top of these reporting duties is a major administrative task, but it is absolutely essential. The specialist Business immigration solicitors at Immigration Solicitors4me can provide training and ongoing support to ensure your HR team understands and meets these critical reporting deadlines.
What is a Home Office Compliance Audit?
The Home Office has the power to check your compliance at any time, often by conducting a visit to your business premises. These audits can be, and frequently are, unannounced. During an audit, compliance officers will want to inspect your record-keeping systems, review the files of your sponsored workers, and may even ask to interview you and the sponsored individuals themselves. They will be checking to ensure that you are meeting all your duties and that your sponsored workers are genuinely performing the roles for which they were sponsored.
The Ultimate Sanction: The Threat of Licence Revocation
If the Home Office finds a serious breach of your sponsor duties, the consequences can be devastating. They have the power to downgrade, suspend, or, in the worst cases, completely revoke your sponsor licence. Revocation is a corporate catastrophe. It means:
- You immediately lose the ability to sponsor any new international workers.
- The visas of all your current sponsored employees will be cancelled, and they will be forced to find a new sponsor or leave the UK, often within 60 days. This can lead to the loss of key, business-critical staff overnight.
Immigration Solicitors4me: Your Compliance and Defence Partner
The best way to manage the sponsor's burden is with expert legal support. The team of Business immigration solicitors at Immigration Solicitors4me acts as a proactive partner to UK businesses. We provide:
- Compliance Audits:We can conduct a "mock audit" of your systems to identify and rectify any weaknesses before the Home Office does.
- Staff Training:We train your key personnel on how to use the SMS and manage their duties effectively.
- Robust Defence:If you are facing a Home Office investigation or the threat of revocation, we provide the expert legal representation you need to defend your licence.
Your sponsor licence is a valuable business asset. Partnering with specialist Business immigration solicitors is the most effective way to protect it. To ensure your business is fully compliant and secure, contact the corporate immigration team at Immigration Solicitors4me today.